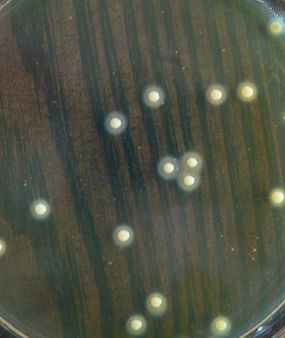
干货课堂|啤酒生产卫生危害 干货课堂|啤酒生产卫生危害

在啤酒酿造过程中,免不了异类微生物的侵害,这些微生物的生长、繁殖,利用麦汁(非常好的培养基)或啤酒中的营养成分,导致后续生产困难或出现异常,使成品啤酒出现沉淀、混浊、甚至其代谢产物导致啤酒风味、口味异变。
接下来一起来看看详细内容吧

糖化阶段
易染菌种类:
适热乳酸杆菌
说明:
糖化初,醪液温度≤50℃时易染,但对降低醪液pH有利;50°C以上,乳酸杆菌不易生长,因此不易染菌。
麦汁冷却至接种过程
易染菌种类:
①大肠菌群
②野生酵母
③醋酸菌、乳酸杆菌
微球菌、枯草杆菌、霉菌、放线菌、变性黄杆菌等
说明:
①大肠菌群在40°C仍可生长,应防止不洁的水混入麦汁中,该菌繁殖极快,7小时内可繁殖几百万倍,感染少量菌即铸成大害,并且不易消灭,连续发酵所使用的间歇麦汁更应注意此菌污染。
②野生酵母常潜伏在管道的缝隙、螺纹、垫料上,当麦汁流经管道易带入;也有重复使用的种酵母中带入的可能,种酵母污染,能与酵母竞争繁殖,发酵完毕前停止生长。
④醋酸杆菌、乳酸杆菌在麦汁中污染,生长较慢,薄板系统死角或卫生不良、杀菌不彻底;无菌风系统感染。
发酵阶段
易染菌种类:
①变性黄杆菌
②巴氏乳酸菌、醋酸菌
③大肠菌群
④野生酵母
说明:
①变性黄杆菌主要在酵母接种时污染,种酵母中一般发起人染有此菌,此菌能使酵母竞争繁殖,在发酵完毕前停止生长。
②巴氏乳酸菌、醋酸菌在接种酵母中常会有此菌,发酵时此两菌可以生长,开口发酵有利于醋酸菌的生长,密闭发酵有利于乳酸菌生长。
③大肠菌群,种酵母中含有此菌。
④野生酵母的主要污染来源是种酵母,尽管按种时污染率很低,们发酵完中,回收的酵母中,野生酵母的污染率就大了。
贮酒阶段
易染菌种类:
①醋酸杆菌
②乳酸杆菌
③发酵单胞菌
④大肠菌群
说明:
发酵罐清洗杀菌不彻底;下酒时贮酒罐、清酒罐及滤酒系统杀菌不彻底;
①下酒或酒液上部存在空气时繁殖快
②在厌氧下生长
③厌氧下发展很快,较少发现
包装阶段
易染菌种类:
醋酸杆菌
乳杆菌
足球菌
发酵单孢菌
大肠菌群
霉菌
说明:
供包装输酒系统、灌装机酒缸、空瓶、空桶等,在包装过程重污染。

并不是所有进入啤酒酿造过程的微生物都是啤酒的有害菌,按其对啤酒的危害情况,可将这些微生物分为两大类
1
无害共生菌
无害共生菌是指霉菌孢子和许多好氧性细菌,它们不能在啤酒中生长,甚至啤酒的特殊环境会使它们窒息;但是若有这些微生物存在,则也说明可能同时会存在有害微生物。
所谓无害于啤酒(相对)的微生物——是指不能在啤酒酿造中繁殖,如一些好样的孢子杆菌不引起啤酒变味混浊的小球菌和微球菌
2
有害菌
有害菌是指人类致病菌(如大肠菌群),或在特定条件下生长、繁殖的而引起啤酒生产过程不正常,或使啤酒酸败、变味、粘稠、沉淀、混浊的这类微生物;
属于有害菌的种属有:野生酵母、乳酸杆菌属、链球菌属、果胶杆菌、巨型球菌属、肠道细菌属等…… !!!
下面为同学们带来几张
微生物的真面目

金黄色葡萄球菌
乳酸杆菌
醋酸杆菌
双球菌
四联球菌
明珠串菌
大肠杆菌
芽孢枯草杆菌
到这里
本期的干货分享也要结束
感谢同学们的认真阅读
也衷心希望同学能有所收获
我们下期再见
澜埔国际酿酒学院
技术咨询电话
13287763383 15662693113
发现更多精彩
关注公众号